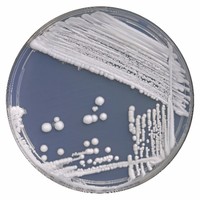
Lesley Thomas

Company Details
- Employees
- 17
- Founded
- -
- Address
- 1950 Tobsal Ct., Warren,mi 48382,united States
- Phone
- +1 800 253 6800
- in****@****san.com
- Industry
- Environmental Services
- NAICS
-
Environmental Consulting Services
- Website
- biosan.com
- Keywords
- CDC ELITE Certified for Legionella Testing, Certified by EPA/State of Michigan DEQ, Antimicrobial Testing of Plastics and Textiles (AATCC, ASTM, JIS and ISO), Preservative and Biocide Efficacy Testing, Microbial Identification, Microbial Test Kits, Legionella.
- HQ
- Warren, MI